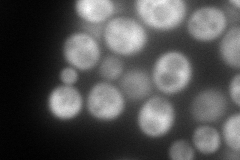
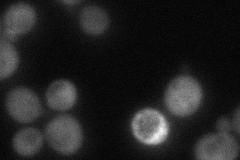
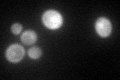

View description
Glucose-6-phosphate dehydrogenase (G6PD), catalyzes the first step of the pentose phosphate pathway; involved in adapting to oxidatve stress; homolog of the human G6PD which is deficient in patients with hemolytic anemia
Localization:
Intensity:
Fold change:
Significance:
-
C’ GFP library in SD

cytosol98.81 -
N' NOP1pr-GFP in SD

cytosol188.529 -
N' TEF2pr-mCherry in SD
cytosol241.94 -
N' NATIVEpr-GFP in SD
cytosol61.0875 -
N' TEF2pr-VC and Cyto-VN in SD

cytosol73.5933 -
C’ GFP library in SD+DTT

cytosol146.941.48Yes -
C’ GFP library in SD+H2O2

cytosol143.851.45Yes -
C’ GFP library in Starvation Media
cytosol157.441.59Yes -
C’ GFP library on the background of Pup2-DaMP

cytosol -
C’ GFP library on the background of CCT mutant

cytosol99.62211.00816No
